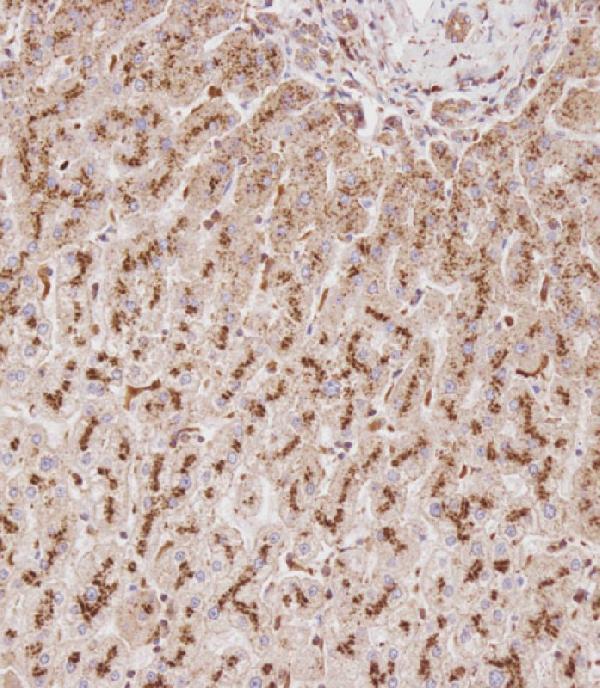
a02234 anti gusb antibody center ihc p testing 2

Product Info Summary
| SKU: | A02234 |
|---|---|
| Size: | 80 µl |
| Reactive Species: | Human, Mouse |
| Host: | Rabbit |
| Application: | Flow Cytometry, IHC-P, WB |
Customers Who Bought This Also Bought
Product info
Product Name
Anti-GUSB Antibody (Center)
SKU/Catalog Number
A02234
Size
80 µl
Description
Boster Bio Anti-GUSB Antibody (Center) (Catalog # A02234). Tested in IHC-P, Flow Cytometry, WB application(s). This antibody reacts with Human, Mouse.
Storage & Handling
Maintain refrigerated at 2-8°C for up to 2 weeks. For long-term storage, store at -20°C in small aliquots to prevent freeze-thaw cycles.
Cite This Product
Anti-GUSB Antibody (Center) (Boster Biological Technology, Pleasanton CA, USA, Catalog # A02234)
Host
Rabbit
Contents
Purified polyclonal antibody supplied in PBS with 0.09% (W/V) sodium azide.
Clonality
Polyclonal
Isotype
Rabbit IgG
Immunogen
This GUSB antibody is generated from rabbits immunized with a KLH conjugated synthetic peptide between 335-362 amino acids from the Central region of human GUSB.
Reactive Species
A02234 is reactive to GUSB in Human, Mouse
Calculated molecular weight
74.7 kDa
Background of GUSB
The GUSB gene encodes beta-glucuronidase (EC 3.2.1.31), a lysosomal hydrolase involved in the stepwise degradation of glucuronic acid-containing glycosaminoglycans (Shipley et al., 1993 [PubMed 7680524]). It is a tetrameric glycoprotein composed of identical subunits (Oshima et al., 1987 [PubMed 3468507]). The GUSB gene is mutated in mucopolysaccharidosis type VII (MPS7; MIM 253220).
Antibody Validation
Boster validates all antibodies on WB, IHC, ICC, Immunofluorescence, and ELISA with known positive control and negative samples to ensure specificity and high affinity, including thorough antibody incubations.
Application & Images
Applications
A02234 is guaranteed for Flow Cytometry, IHC-P, WB Boster Guarantee
Recommend Dilution
WB: 1:4000
IHC-P: 1:100
FC: 1:10-1:50
Validation Images & Assay Conditions

Click image to see more details
All lanes : Anti-GUSB Antibody (Center) at 1:4000 dilution
Lane 1: HT-29 whole cell lysate
Lane 2: WiDr whole cell lysate
Lane 3: K562 whole cell lysate
Lane 4: A2058 whole cell lysate
Lane 5: HL-60 whole cell lysate
Lane 6: Mouse liver tissue lysate
Lane 7: Mouse lung tissue lysate
Lysates/proteins at 20 µg per lane.
Secondary
Goat Anti-Rabbit IgG, (H+L), Peroxidase conjugated at 1/10000 dilution.
Predicted band size : 75 kDa
Blocking/Dilution buffer: 5% NFDM/TBST.
Click image to see more details
Immunohistochemical analysis of A02234 on paraffin-embedded Human liver tissue. Tissue was fixed with formaldehyde at room temperature. Heat induced epitope retrieval was performed by EDTA buffer (pH9. 0). Samples were incubated with primary antibody (1:100) for 1 hour at room temperature. Undiluted CRF Anti-Polyvalent HRP Polymer antibody was used as the secondary antibody.

Click image to see more details
Immunohistochemical analysis of A02234 on paraffin-embedded Human colon carcinoma tissue. Tissue was fixed with formaldehyde at room temperature. Heat induced epitope retrieval was performed by EDTA buffer (pH9. 0). Samples were incubated with primary antibody (1:100) for 1 hour at room temperature. Undiluted CRF Anti-Polyvalent HRP Polymer antibody was used as the secondary antibody.

Click image to see more details
GUSB Antibody (Center) (Cat. #A02234) flow cytometric analysis of WiDr cells (right histogram) compared to a negative control cell (left histogram). FITC-conjugated goat-anti-rabbit secondary antibodies were used for the analysis.
Specific Publications For Anti-GUSB Antibody (Center) (A02234)
Loading publications
Recommended Resources
Here are featured tools and databases that you might find useful.
- Boster's Pathways Library
- Protein Databases
- Bioscience Research Protocol Resources
- Data Processing & Analysis Software
- Photo Editing Software
- Scientific Literature Resources
- Research Paper Management Tools
- Molecular Biology Software
- Primer Design Tools
- Bioinformatics Tools
- Phylogenetic Tree Analysis
Customer Reviews
Have you used Anti-GUSB Antibody (Center)?
Share your experimental results or join a short interview to earn up to $1,000 in product credits or other rewards.
0 Reviews For Anti-GUSB Antibody (Center)
Customer Q&As
Have a question?
Find answers in Q&As, reviews.
Can't find your answer?
Submit your question




